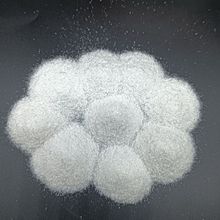
�F؛����ѩ���׼���ɳ ˮ̎��ʯӢɰ �������ü���ʯӢɰ

共 110件
朝陽石英粉
相關產品
所有類目
-
批發煅燒微細硅微粉 冶金礦產高純度石英粉 4000目塊狀熔融硅微粉
-
廠家供應遼寧硅微粉425目 1250目 3000目 橡膠 塗料透明硅微粉
-
精制石英砂 環氧樹脂漆地坪噴砂草坪高純雪花白沙子 石英沙石英粉
-
石英砂廠家批發白色沙子肌理畫用白沙 魚缸造景人造沙灘雪花白沙
-
魚缸純白煙灰50砂煙灰缸酒店沙石英砂斤白沙垃圾沙石細沙石英垃圾
-
石英砂草坪砂雪花白沙噴砂除銹鑄造石英砂水處理板材普通石英砂
-
供應純白石英砂 白石英砂 地坪板材用白沙
-
廠家供應硅砂 精密鑄造用高白石英砂60-80目石英粉
-
自家礦山石英石板A+砂低吸油脂降本增效白板板板材超白石英砂
-
廠家供應石英粉鑄造塗料用石英粉瓷釉制輥防火塗料用低鐵硅微粉
-
廠家批發精制石英砂石英粉噴砂爐料 玻璃 鑄造 塗料用高硅砂
-
石英沙子造景滅煙沙鑄造石英砂顆粒煙灰沙過濾砂石頭噴砂白沙造景
-
石英砂濾料水處理高硅精致石英砂噴砂除銹石英粉肌理砂白沙子
-
精制石英砂 環氧樹脂漆地坪噴砂草坪高純雪花白沙子 石英沙石英粉
-
源頭廠家石英砂批發水處理石英砂濾料玻璃砂石英粉硅砂粗沙細沙
-
冰箱貼石英砂貝殼畫肌理畫手工diy材料包配件文創自制作趣味玩具
-
石英砂用於 水處理濾料 噴砂除銹 鑄造 污水過濾規格全
-
10斤純白石英砂白色細沙水處理白沙過濾白砂酒店垃圾桶煙灰缸造景
-
斤純白石英砂白色細沙水處理白沙過濾白砂酒店垃圾桶煙灰缸造景
-
水產養殖 過濾 熔融焊條添加劑 石英砂
-
10斤純白石英砂白色細沙水處理白沙過濾白砂酒店垃圾桶煙灰缸造景
-
10斤純白石英砂白色細沙水處理白沙過濾白砂酒店垃圾桶煙灰缸造景
-
10斤純白石英砂白色細沙水處理白沙過濾白砂酒店垃圾桶煙灰缸造景
-
石英砂顆粒 天然石英砂濾料泳池浴池沙缸水過濾噴砂除銹草坪用沙
-
肌理砂石英砂白沙水處理石英砂濾料噴砂除銹草坪雪花白石英砂硅砂
-
石英砂廠家兒童沙池白沙水處理外牆真石漆塗彩砂PC透水磚石英砂
-
現貨批發遼寧硅微粉425目 1250目 6000目 橡膠 塗料透明硅微粉
-
現貨供應污水水處理濾料用石英砂鑄造用石英砂兒童娛樂用石英砂
-
廠家供應石英砂石英石板材噴砂普砂污水過濾全目數低吸油脂高純
-
供應各種規格石英砂 噴砂除銹耐磨 水處理濾料 鑄造用石英砂
-
過濾10處理純白斤石英砂造景白砂白色細沙白沙酒店垃圾桶煙灰缸水
-
石英砂顆粒泳池浴池砂缸過濾水廠濾池噴砂除銹天然石英砂濾料
-
廠家供應遼寧硅微粉425目 1250目 6000目 橡膠 塗料透明硅微粉
-
現貨供應雪花白肌理沙 水處理石英砂 肌理畫用純白石英砂
-
石英砂水處理濾料抗酸鹼性截污能力強建築石英砂北京石英砂廠家
-
高白砂精砂A砂金砂礦山直發純白石英砂高透砂奢石板材砂鑄造砂
-
白沙子 丙烯畫畫肌理砂酒店造景用雪花白砂子 兒童游樂園用石英砂
-
石英砂顆粒水處理濾料用各種規格石英砂噴砂除銹人造草坪用石英砂
-
自家礦山天意石英砂板材鑄造工業濾料普砂26-40目40-70目70-120目
-
石英砂廠家 球場 濾料 地面砂 網紅沙灘 兒童娛樂砂廠家現貨供應
1
2